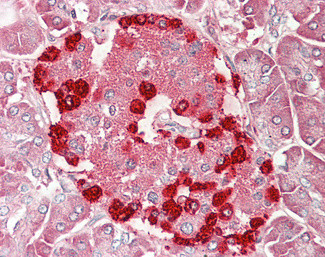
TSPYL2 Antibody in Immunohistochemistry (Paraffin) (IHC (P))

Search
Invitrogen
TSPYL2 Polyclonal Antibody
{{$productOrderCtrl.translations['antibody.pdp.commerceCard.promotion.promotions']}}
{{$productOrderCtrl.translations['antibody.pdp.commerceCard.promotion.viewpromo']}}
{{$productOrderCtrl.translations['antibody.pdp.commerceCard.promotion.promocode']}}: {{promo.promoCode}} {{promo.promoTitle}} {{promo.promoDescription}}. {{$productOrderCtrl.translations['antibody.pdp.commerceCard.promotion.learnmore']}}
产品信息
PA5-142840
种属反应
宿主/亚型
分类
类型
抗原
偶联物
形式
浓度
规格
纯化类型
保存液
内含物
保存条件
运输条件
RRID
产品详细信息
This antibody is tested in Peptide ELISA: antibody detection limit dilution 1:64,000.
靶标信息
This gene encodes the beta-subunit of glucosidase II, an N-linked glycan-processing enzyme in the endoplasmic reticulum (ER). This protein is an acidic phospho-protein known to be a substrate for protein kinase C. Mutations in this gene have been associated with the autosomal dominant polycystic liver disease (PCLD). Alternatively spliced transcript variants encoding distinct isoforms have been observed.
仅用于科研。不用于诊断过程。未经明确授权不得转售。
篇参考文献 (0)
生物信息学
蛋白别名: CASK-interacting nucleosome assembly protein; CDA1; cell growth/division inhibitor; Cell division autoantigen 1; CTCL tumor antigen se20-4; CTCL-associated antigen se20-4; Cutaneous T-cell lymphoma-associated antigen se20-4; cutaneous T-cell lymphoma-associated tumor antigen se20-4; differentially expressed nucleolar TGF-beta1 target; Differentially-expressed nucleolar TGF-beta1 target protein; HRIHFB2216; NP79; Nuclear protein of 79 kDa; RP1-290F12.2; testis-specific protein Y encoded-like 2; Testis-specific Y-encoded-like protein 2; TGF-beta1-regulated protein; TSPY-like protein 2; unnamed protein product
基因别名: CDA1; CINAP; CTCL; DENTT; HRIHFB2216; NP79; SE204; TSPX; TSPYL2
UniProt ID: (Human) Q9H2G4
Entrez Gene ID: (Human) 64061